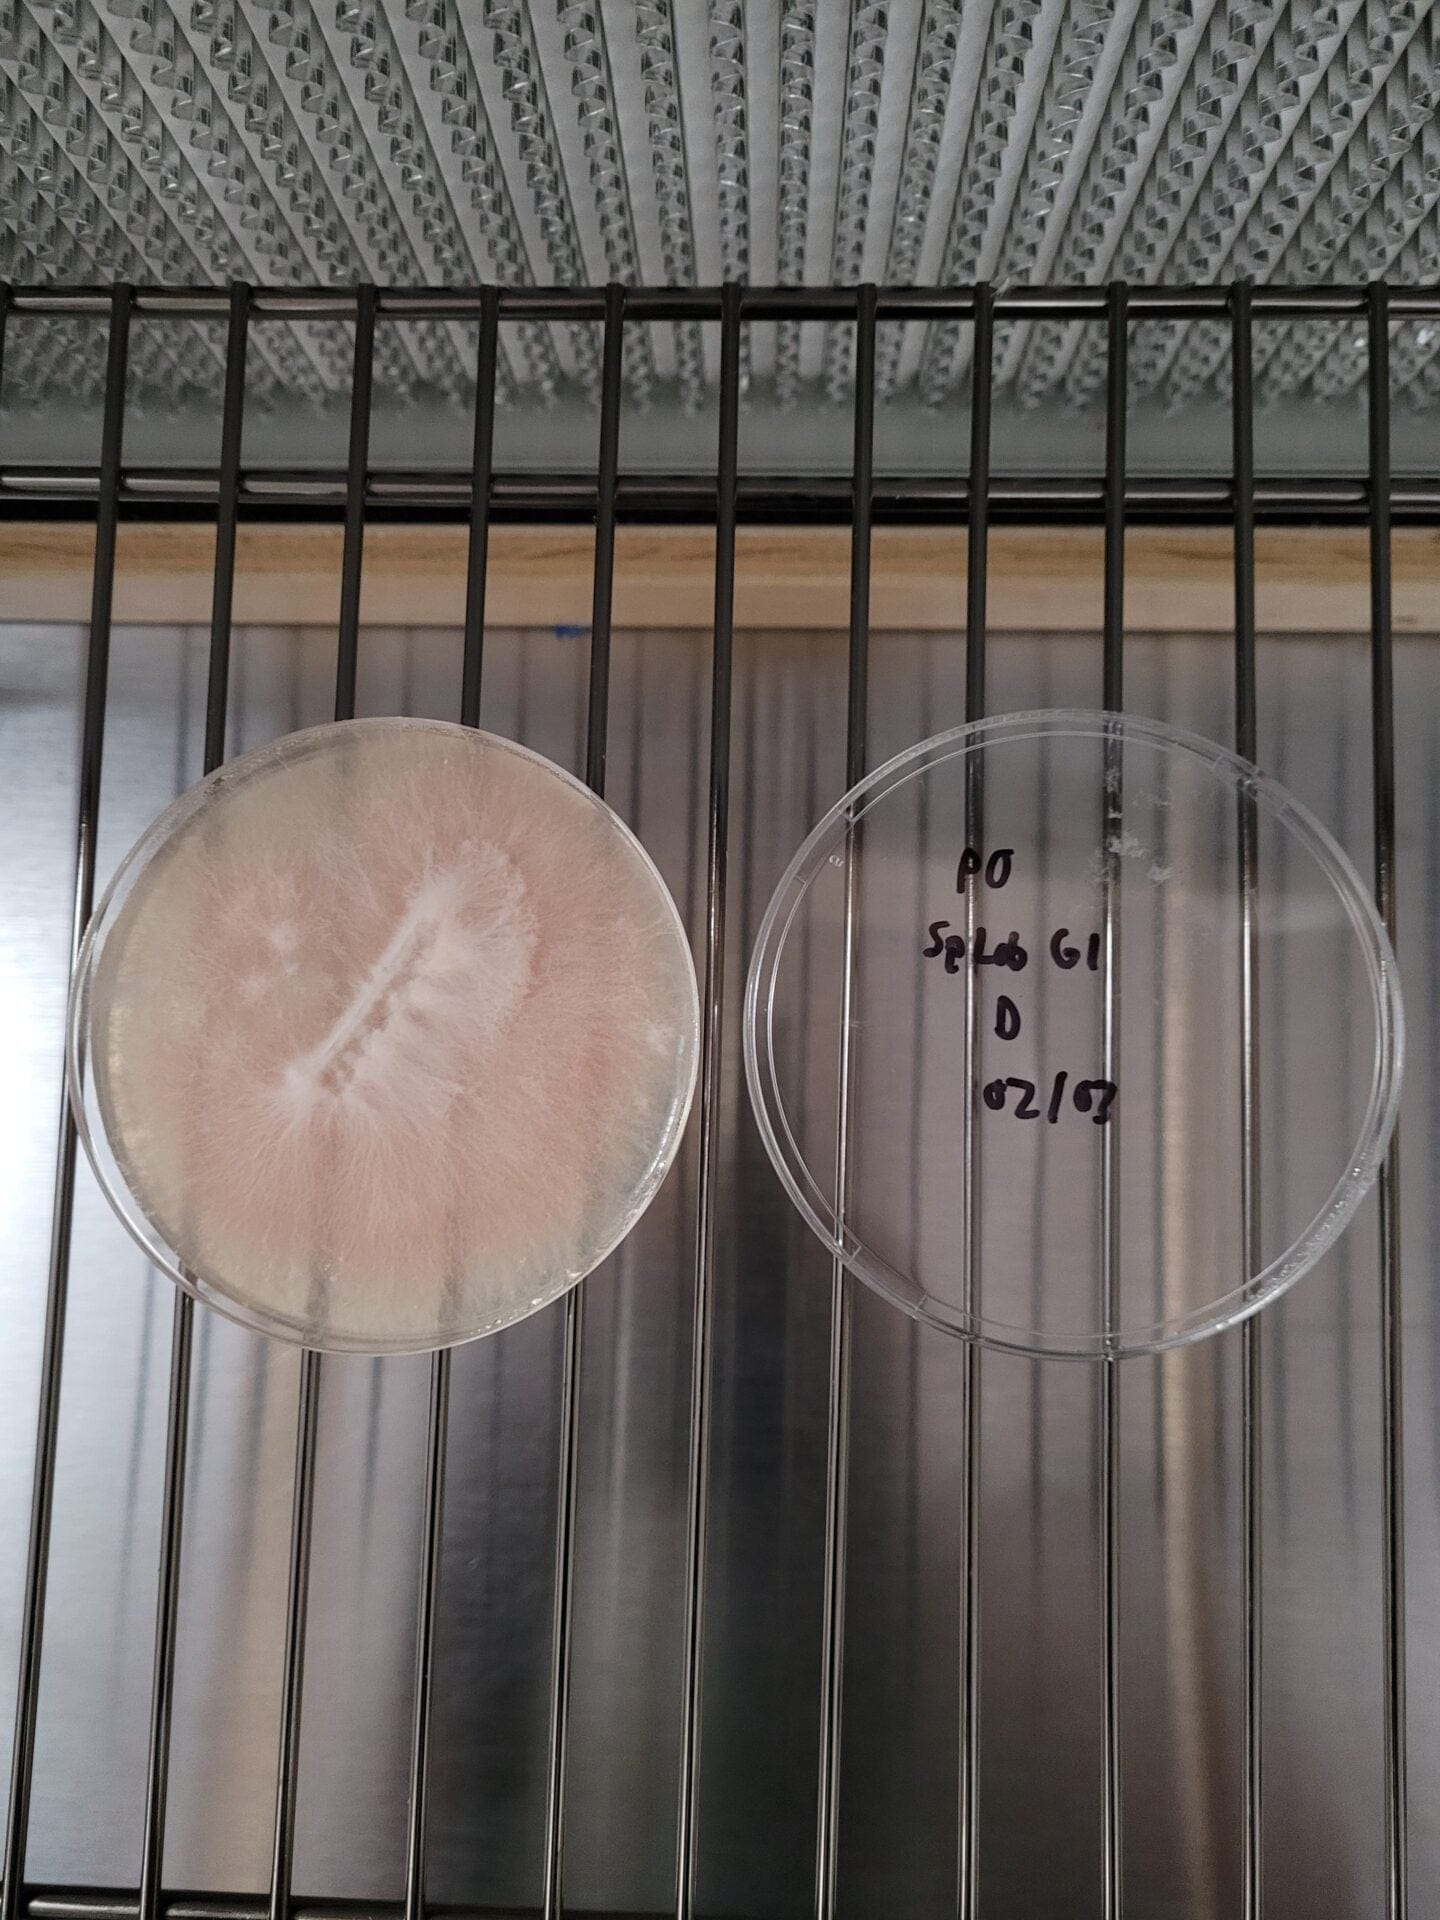

Circular Harvest
Pink Oyster (Pleurotus djamor) Agar Culture
Pink Oyster (Pleurotus djamor) Agar Culture
Couldn't load pickup availability
The Pink Oyster mushroom is native to tropical regions like Indonesia and central Mexico, it is a saprotroph that acts as a primary decomposer of wood. Therefore, when growing Oyster mushrooms indoors one must use a hardwood-amended substrate. Oysters, along with Lions Mane, are some of the easiest mushrooms species to grow, so are both a great choice for a beginner grower!
Due to their tropical origin they prefer warmer temperature around 20-25C. It is not recommended to refridgerate this culture due to this characteristic as you run the risk of killing the mycelium.
The flavor of the pink oyster mushroom has been described as meaty and fishy. Just like most mushrooms it is quite umami. Its texture is both meaty and chewy. When fried until crispy, it resembles bacon or even ham. However, when it is raw, it has a sour taste.The pink oyster mushroom, unsurprisingly, has a pink color. It has a curly cap which is 2 – 5 cm in diameter. The caps are also quite thin. The stem is very short or even non existent.
Adding this agar culture to our sterilized rye grain will produce high quality grain spawn that can be used to inoculate a wood based sterilized substrate.
The Pink Oyster isolate is grown on agar in a parafilm-wrapped 90x20mm petri dish. Our agar is made with agar agar powder which is food grade with a high gel strength of 900g/cm2. We add light dry malt extract powder to our agar mixture to help promote growth of the mycelium. The malt extract is of the highest quality, sustainably sourced and made for brewing
Share